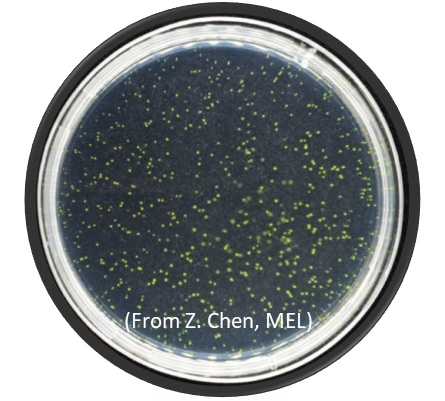

原标题:打破固有认知!厦大团队耗时四年揭示原绿球藻的进化奥秘
来源:厦门大学大年初六,在短暂地与家人团聚后,厦门大学海洋与地球学院的博士生陈卓宇已经早早收拾好行囊,准备返校。
从2018年开始,他的每个春节几乎都在实验室度过,即便返乡,时间也很短暂,因为他的心里始终牵挂着厦园里那些陪伴了他四年的“战友”,他的实验材料——原绿球藻。

△ 陈卓宇在做实验
当生态学遇上进化
早在几亿年前,原绿球藻就生活在地球上了,它的“祖先”更是早在约25亿年前就开始进化,并在许多方面改变了地球。它们吸收并利用阳光中的能量,从水中分离出氧和氢,氧气便开始在大气中积累,给原本“缺氧”的地球带来了繁荣的“大氧化”时代,为后续生物进化的高速发展提供了重要条件。
而今,作为海洋里最重要的初级生产者,原绿球藻通过光合作用每年固定约40亿吨碳,是“海洋碳汇”的重要贡献者。
然而,如此重要的生物,却因为太小,仅在三十多年前才被人类发现。
陈卓宇的导师,张瑶教授介绍道:“其实1毫升的大洋海水里,就有多达10万个原绿球藻。但因为它实在是太小了,从前落后的设备和技术无法观测到,人们才这么晚认识到它。”

△ 原绿球藻
早在厦大读博期间,张瑶就在导师焦念志院士的带领下,迈入了“海洋微生物生态”研究领域的大门。毕业后留校任教的她,延续了多年的研究方向,潜心钻研海洋生态学,原绿球藻就是她的主要研究对象之一。她知道,作为地球演化过程中极其重要的生物以及当今海洋里最重要的初级生产者,原绿球藻具有无可替代的进化和生态学意义。
五年前,张瑶在一次与香港中文大学罗海伟教授的交谈中,两人一拍即合,迅速达成合作意向。“我是做生态的,他是做进化的,我们当时聊完就觉得,如果能一起把海洋里如此重要的生物(原绿球藻)从‘进化生态学’的角度做清楚,那一定能做出相当重要的贡献。”
于是研究正式启动,当时刚刚从厦大本科毕业并留校读博的陈卓宇便作为主力,开启了长达四年的实验。
“报告打得最多的人”
“培养原绿球藻”,看似简单的第一步,成为了陈卓宇面临的首道难题。
“原绿球藻非常难养,甚至早期学界都认为它‘不可培养’,经过多年的摸索,如今全世界也只有屈指可数的实验室能把它成功养活,固体培养更是难上加难。”培养基所使用的海水、固体培养基的琼脂糖浓度、培养时设置的光照强度和温度……这些因素的细微变动都可能对原绿球藻的生长产生巨大影响。


△ 在平板上生长的原绿球藻
在一次次尝试中,陈卓宇不断调试实验参数,并在香港科技大学曾庆璐教授的联合指导下,最终成功克服了原绿球藻难以在实验室培养的困难,摸索出了一套稳定的单克隆培养方案。
但很快,他又面临着下一道难题——长时间地连续传代。该研究的时长取决于原绿球藻在传代中基因突变的数量,只有累积到一定的数量,才能进行有效的统计分析。然而,原绿球藻生长周期较长,而他们在实验中又发现,原绿球藻基因突变的速率很慢,这在颠覆了学界认知的同时,也使得实验的时长跨越了四年之久。

△ 原绿球藻的传代实验
四年里,陈卓宇成为了学院里“报告打得最多的人”。受疫情影响,近年我校严格校园管理。在校园和实验室短期严管人员流动时,陈卓宇一次次提出返校、进入实验室的申请,作为导师的张瑶则一次次地帮他签字、提交申请。
累积培养1065天,连续传代39次,最终存活141个细胞系……实验就在这一次次的“申请报告”中顺利完成了。
“科学是在不断修正中发展的”
原绿球藻数量庞大、分布广泛。而“遗传漂变”是种群基因库在代际发生随机改变的一种过程,通常在小群体里尤为明显。多年来,学界一直默认原绿球藻有效种群规模很大,进而认为自然选择在原绿球藻进化适应过程中极其有效,忽略了遗传漂变的作用。
然而,该研究计算出原绿球藻的有效种群规模仅为1.68 × 107,小于许多典型的海洋自由生活菌;进一步分析发现,原绿球藻虽分布广泛,但不同的小生境被不同代谢特点的孤立种群所占据。“就像是生活在不同地区的人群,适应其所在的环境,拥有不同的特征。”但同时各种群之间彼此孤立,不发生基因交流,种群内部基因重组水平较低。
因此,研究提出了“周期性选择”的原绿球藻遗传漂变加强机制,给寡营养海域中优势菌群常见的基因缩减现象,在传统的“寡营养环境适应”观点之外,提供了一种创新的观点和理论。
该研究证明,在原绿球藻进化过程中,人们所熟知的“自然选择”并不如传统认知的那么重要,而一直被忽略的“遗传漂变”发挥着关键作用。

△ 论文配图:核生物基因组大小(G)、碱基替换速率(μ)、全基因组突变速率(Up)、有效种群数量(Ne)之间的相互关系
“这个世界上有这么多的物种,它们并不一定都是自然选择选出的佼佼者,有些物种它可能只是幸运地存活了下来而已。虽然大众已经普遍理解并笃信了‘自然选择’的作用,但我们不能因此就忽视了‘遗传漂变’的作用。”该研究的一系列发现,打破了学界对原绿球藻进化的固有认知。
张瑶说:“我们获得的实验结果,有的符合已有的理论,有的不符合。这是因为理论并非真理,它始终处在动态发展的过程中,需要我们不断地验证、修正它。科学就是这样,就是在不断修正中发展的。”

△ 张瑶在实验室指导学生
近日,该研究以“Prochlorococcus have low global mutation rate and small effective population size”为题在国际顶级期刊 Nature Ecology & Evolution(《自然·生态与进化》)上刊发。陈卓宇和香港中文大学王晓君博士为论文共同第一作者,张瑶教授和香港中文大学罗海伟教授为论文共同通讯作者。
苦心耕耘的实验虽已结出硕果,但研究还将延续。“我们会继续坚持这141个细胞系的传代工作,未来计划围绕‘全球变化’领域拓展研究。”在他们心中,科学没有终点,探索也将永不止步。



